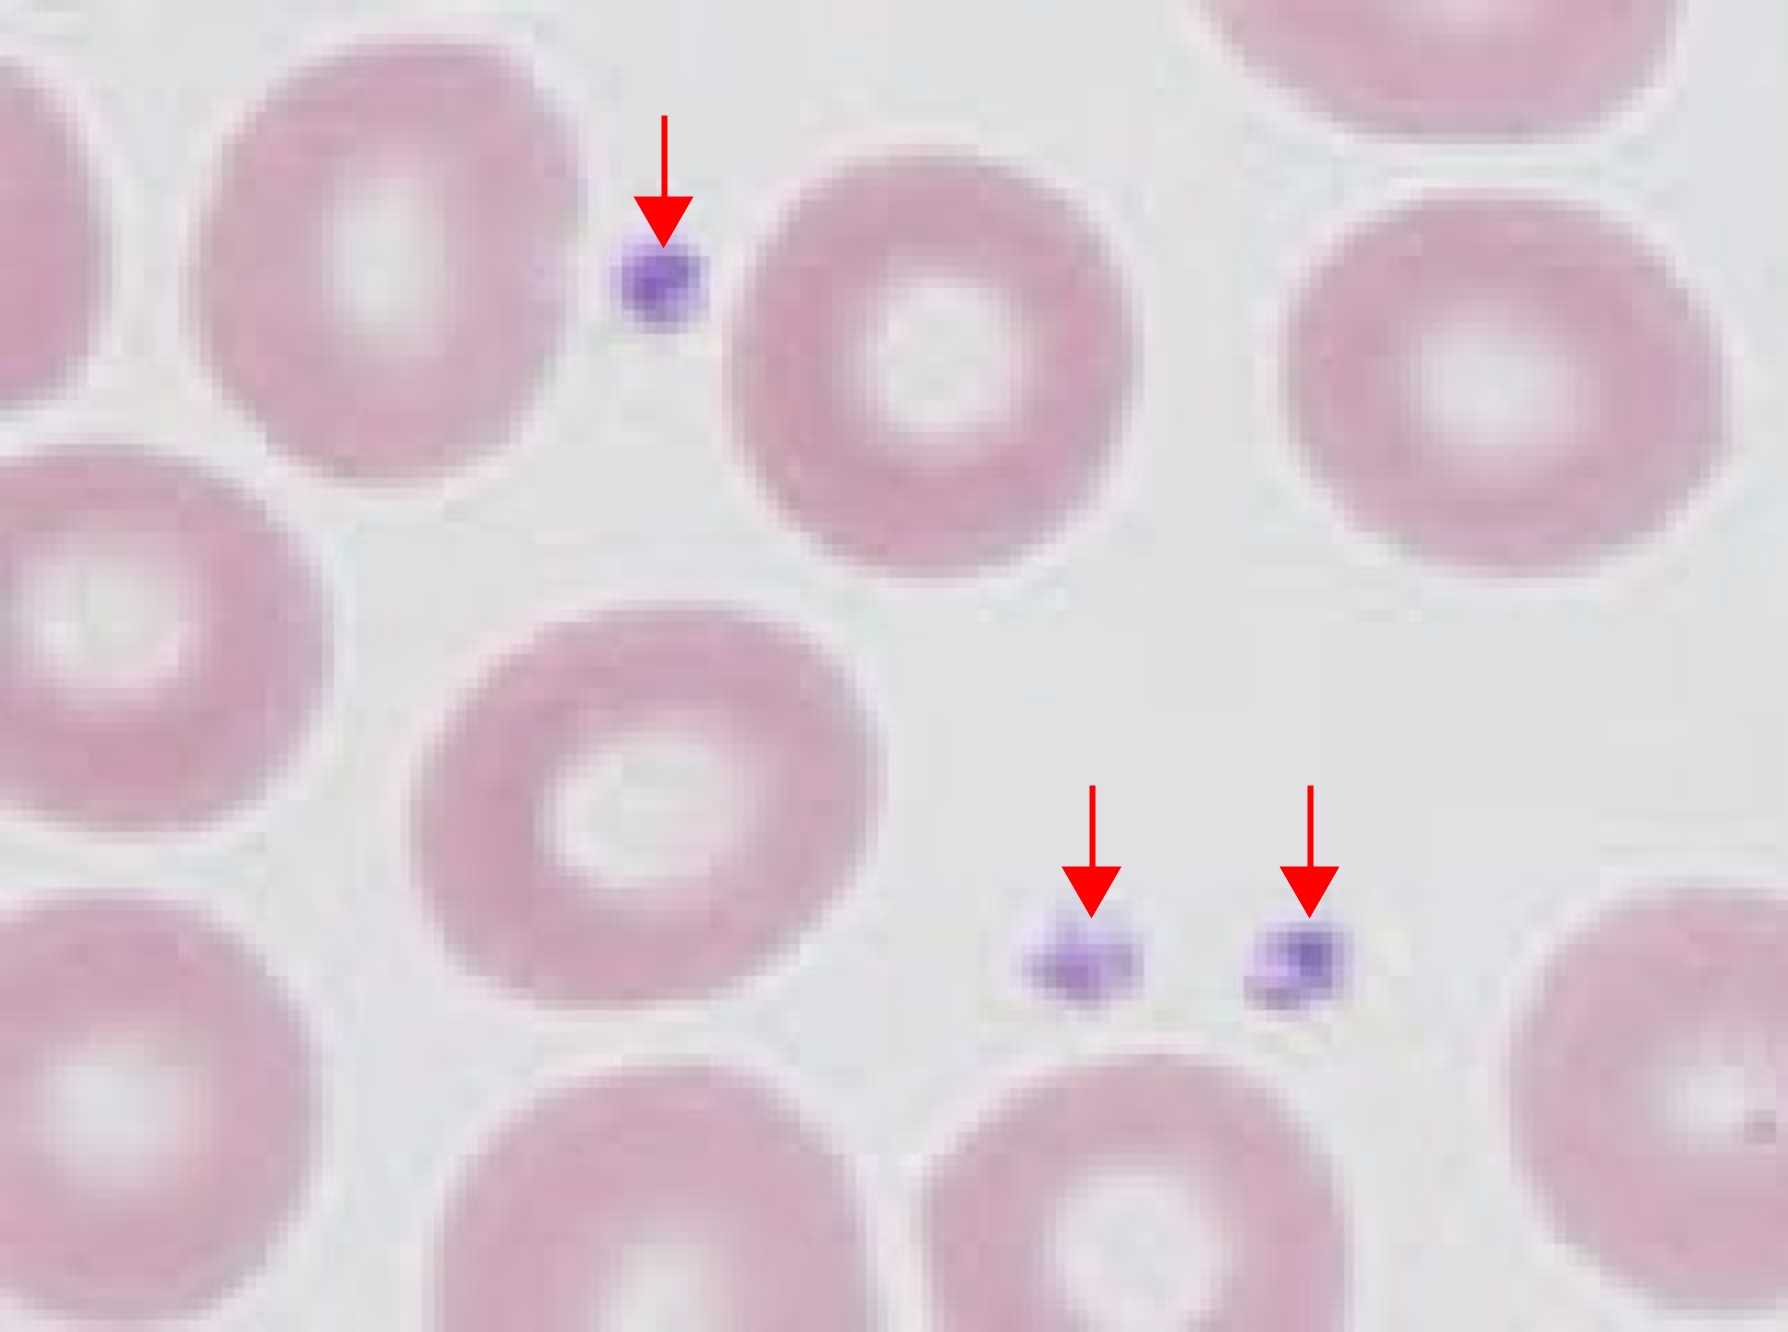

/ 中央検査科
(1) 血液中の血球の検査、(2)血液凝固系の検査を行っています。
白血球、赤血球、血小板の数、ヘモグロビンの濃度等を測定します。

| 項目名 | 基準値 | 単位 | 備考 |
|---|---|---|---|
| 血算 WBC (白血球数) |
3300 ~ 8600 | /μl | 感染を防ぐ免疫の働きをします。 感染症、炎症、血液疾患などで高値となります。 |
| 血算 RBC (赤血球数) |
男:435 ~ 555 女:386 ~ 492 |
×104/μl | 酸素を運ぶ細胞です。貧血の原因や種類を判断します。 貧血、血液疾患などによって、基準値から外れることがあります。 |
| 血算 Hb (ヘモグロビン、血色素量) |
男:13.7 ~ 16.8 女:11.6 ~ 14.8 |
g/dl | 赤血球に含まれる色素で、全身の細胞へ酸素を運びます。 貧血などによって、低値となります。 |
| 血算 Ht (ヘマトクリット) |
男:40.7 ~ 50.1 女:35.1 ~ 44.4 |
% | 血液中に含まれる赤血球の割合を%で表した数値です。 貧血などで低値となり、脱水や激しい下痢などで高値となります。 |
| 血算 MCV (平均赤血球容積) |
83.6 ~ 98.2 | fl | 赤血球の大きさの平均値です。 赤血球の大小が分かり、貧血の原因、分類に役立ちます。 |
| 血算 MCH (平均赤血球血色素量) |
27.5 ~ 33.2 | pg | 赤血球1個あたりに含まれるヘモグロビン(血算Hbの値)の 平均値を表します。 |
| 血算 MCHC (平均赤血球血色素濃度) |
31.7 ~ 35.3 | % | 赤血球容積に対するヘモグロビン(血算Hbの値)の量を表します。 貧血の分類に役立ちます。 |
| 血算 PLT (血小板数) |
15.8 ~ 34.8 | ×104/μl | 出血した部位に集まって止血する働きがあります。 止血能力の指標となり、減少すると血が止まりにくくなります。 |
血液の標本を作製して、顕微鏡で白血球分類や赤血球、血小板の形態を観察します。これらの検査は貧血や血液疾患の診断、その他各種疾患の診断補助になります。
赤血球は、直径7~8μmの大きさで中央が両面からくぼんだ円盤状の形をしています。厚さは厚いところで約2μmあります。
血小板(←)は、直径2~3μmの小さい細胞です。
好中球・好酸球・好塩基球・単球・リンパ球の5種類の白血球があります。
好中球

好中球のおもな機能は、生体に侵入する感染病原体や異物に対する防衛反応です。異物を、貪食、消化、殺菌します。
好酸球

好酸球はアレルギー反応・抗原抗体反応に関与しています。
好塩基球

好塩基球はヒスタミンやヘパリンを放出して即時アレルギー反応を起こします。
単球

単球は、好中球と同じく貪食能をもち、また、血液から組織に出てマクロファージとなり、老廃物や異物を処理します。また抗原と接触するとその情報を免疫担当細胞であるリンパ球に伝達します。
リンパ球

リンパ球は、異物の侵入から身体を守る免疫機能に関与しています。リンパ球には、B細胞、T細胞、NK細胞があります。
血管が傷ついて出血したとき、身体は出血を止める反応を起こします。血液中には血液を固まらせたり、また血中にできた血栓を溶かしたりする機能を持つ成分が含まれています。
これらの機能を検査しています。

血液凝固自動分析装置CP3000
| 検査項目 | 基準値 | 単位 | 備考 |
|---|---|---|---|
| APTT (活性化部分トロン ボプラスチン時間) |
24.0 ~ 39.0 | 秒 | 凝固異常を調べる検査です。血友病などの出血性疾患やヘパリン療法の治療効果の判定に必要な検査です。 |
| PT(プロトロンビン時間) | 80 ~ 120 | % | 凝固異常を調べる検査です。 ワーファリン治療時の効果判定に必要な検査です。 肝機能の悪い時にも異常値となる為、肝機能の指標にもなります。 |
| PT-INR(プロトロンビン時間 標準比) | 0.85 ~ 1.15 | ||
| フィブリノーゲン | 200 ~ 400 | mg/dl | 凝固異常を調べる検査です。 大量出血や肝障害で低値、感染症や炎症などで高値となります。 |
| D-dimer( D-ダイマー ) | 0.0 ~ 1.0 | μg/ml | 凝固異常、血栓症の診断に用いられる検査です。 血栓溶解療法などの経過観察の指標となります。 DIC(播種性血管内凝固症候群)、血栓症などで高値となります。 |
| 血中FDP | 0.0 ~ 4.9 | μg/ml | |
| ATⅢ(アンチトロンビンⅢ) | 凝固反応を抑制します。 血管内で血液の凝固が起こっていると低下します。 |
||
| 超迅速フィブリノゲン | 危機的出血および止血モニタリングの指標です。 |